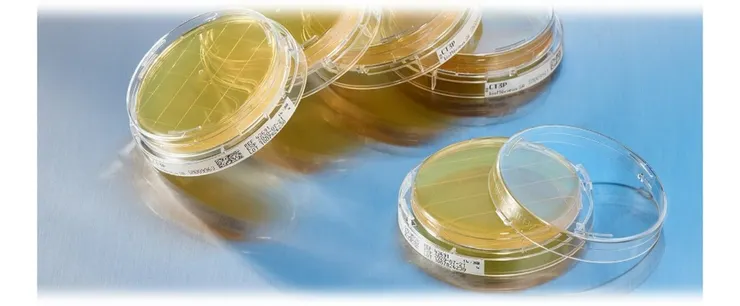
vocus｜新世代的創作平台

在胚胎實驗室中所使用的產品,尤其是培養液等試劑,都一定需要要求產品的品質控制需要非常嚴格。尤其是人類胚胎對 pH 值、滲透壓、溫度和化學成分的波動非常敏感,因此培養液的品質也會是決定臨床結果的關鍵因素之一。為了降低這些風險,生產廠商從原料採購到最終產品放行,整個生產過程中都需要嚴格的品質管制。
生產醫療器材的廠商,需符合和通過嚴格的國際品質管制標準:
品質管制系統認證 ( Quality Management System Certifications)
◦ ISO 13485:2016: 醫療器材品質管理系統的國際標準。
◦ ISO 13408-1:2018: 醫療保健產品無菌處理的標準。
◦ ISO 14644: 無塵室及相關受控環境的標準。
ISO/IEC 17025:2017: 測試與校正實驗室能力之通用國際標準
針對胚胎實驗室產品關鍵的品質管制 QC 項目:
- 小鼠胚胎檢測 (Mouse Embryo Assay - MEA)

MEA 是一項評估各種物質對發育毒性的關鍵品質管制項目,在 ART胚胎實驗室中的試劑、耗材、儀器等的監管審批流程中扮演著核心角色。該檢測將小鼠胚胎暴露於待測產品中,直接評估其對胚胎發育的潛在影響。透過 MEA,我們能夠識別任何可能對胚胎發育構成風險的因素,為產品的安全性提供強而有力的生物學證據。儘管MEA 依賴人工觀察,這種方法容易產生因不同操作者對胚胎評分的不同所產生偏差,也限制了檢測效率,但它仍然是監管機構評估產品安全性的重要依據。
- 人類精子活動力檢測 (Human Sperm Motility Assay - SMA)

此項檢測目的在評估培養液與耗材等對人類精子活動力的影響。透過將精子在產品中進行培養並在不同時間點評估其活動力與生存能力,確保產品不會對成功受精至關重要的精子功能產生任何不利影響。
- 內毒素測試 (Endotoxin Testing – LAL)

細菌內毒素即使在極低的濃度下,也可能引發炎症反應,損害胚胎的生存能力。檢測內毒素使用的是 Limulus Amebocyte Lysate,鱟試劑檢測,因此通常簡稱為 LAL test。主要有兩種檢測方法:
凝膠法 (Gel-Clot Method):最傳統的檢測方法,透過觀察是否形成凝膠塊來定性或半定量內毒素。
動態濁度法 (Kinetic Turbidimetric):透過監測反應過程中混濁度的變化來定量內毒素。

製造廠內重要的品質管制QC項目:
- 環境監控與水質測試 Environmental Monitoring (EM) & Water Testing
為確保無菌的生產條件,對生產區與 QC 測試區的空氣、物體表面及人員進行定期監控。透過沉降菌落盤、主動式空氣採樣器與粒子計數器,嚴格控制環境中的微生物與懸浮粒子,確保其符合 ISO 5 至 7 級無塵室的標準。
此外,用於製造培養基的純化水也須經過嚴格的品質檢查,包括微生物計數、內毒素含量及電導率測試,確保其純度達到最高標準。
- pH 值與滲透壓 pH & Osmolarity
pH 值與滲透壓是影響胚胎發育的兩個最關鍵的物理化學參數。任何微小的偏差都可能對胚胎的生存能力造成負面影響。因此,需使用經過精密校準的數位 pH 計 (具備溫度與二氧化碳補償功能) 和先進的蒸氣壓或冰點下降式滲透壓儀來進行測量。每一批次的產品都必須落在特定配方所驗證的嚴格範圍內。
- 藥物成分定量 Medicinal Quantification
培養液中的特定藥物成分,如 Gentamicin、Heparin 或 Insulin 等,其濃度必須精確。濃度過高可能產生毒性,過低則無法達到預期效果。可利用高效液相層析法 (HPLC) 或酵素免疫分析法 (ELISA) 等特定技術,準確驗證這些關鍵成分的濃度,確保產品既安全又有效。
- 顏色與透明度 (Color and Clarity)
顏色與透明度的目視檢查是一項基礎但至關重要的品質管制步驟。此測試能夠及早發現潛在問題,如微生物污染、化學不穩定或配方錯誤。顏色或透明度的任何變化都可能指示產品降解或成分濃度不正確。透過對比標準品進行嚴格的目視與儀器評估,確保每一批次產品的外觀均一,並符合既定的產品規格。
- 無菌和內毒素檢測 (Sterility and Endotoxin Testing)
無菌性測試有助於確保培養液中不含任何微生物汙染的最終驗證,這對於維持胚胎培養環境的完整性至關重要。 內毒素檢測可檢測細菌內毒素的存在,細菌內毒素會引發發炎反應並損害胚胎活力。
內容參考:
CooperSurgical - Rooted in Excellence: CooperSurgical is Committed to Reaching Above and Beyond Industry Standard













